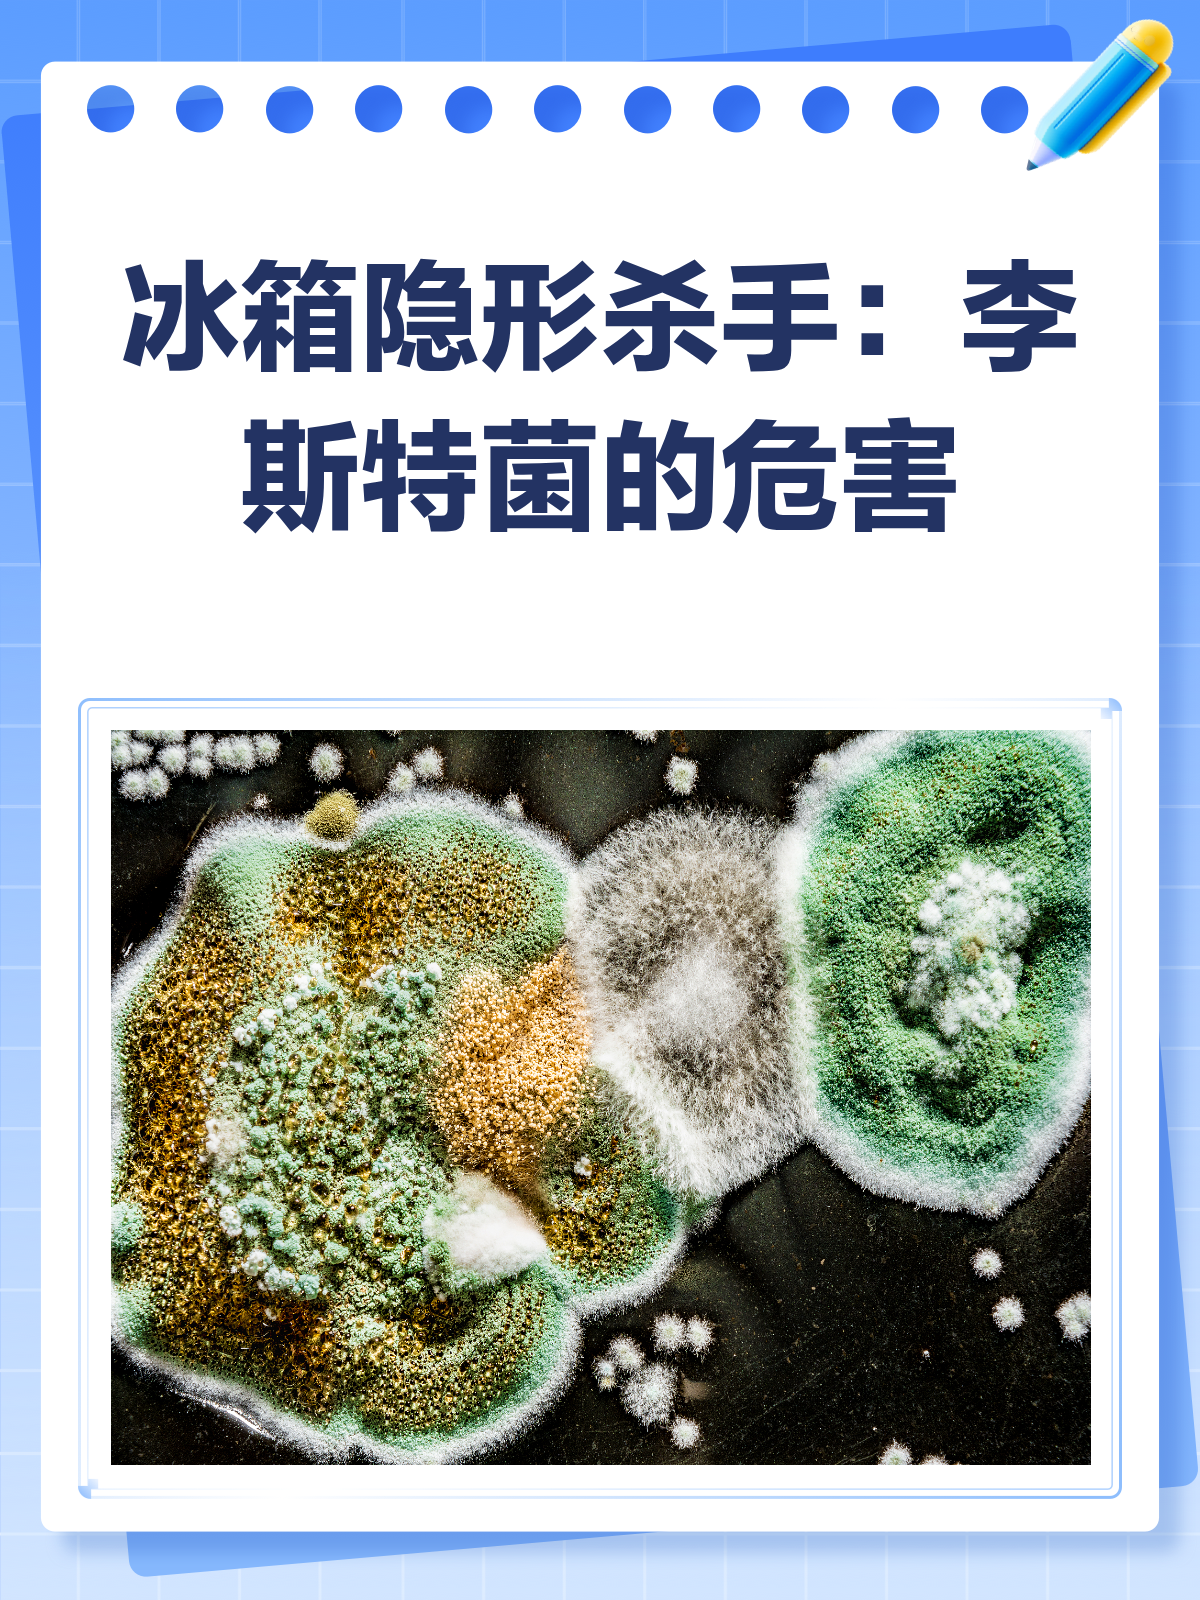
冰箱里的李斯特菌,竟是健康隐形杀手?

李斯特菌 冰箱

李斯特菌冰箱
图片尺寸720x960
李斯特菌揭秘,冰箱隐患知多少?
图片尺寸1080x1263
李斯特菌冰箱
图片尺寸720x960
夏季冰箱"李斯特菌"大揭秘 🌞🧊
图片尺寸2303x3031
冰箱里的李斯特菌,竟是健康隐形杀手?
图片尺寸1200x1600
冰箱李斯特菌的特点及危害
图片尺寸1242x828
孕妇吃冰箱里的李斯特菌
图片尺寸720x960
李斯特菌:冰箱里的隐形杀手
图片尺寸1280x1676
吃了从冰箱里拿出来解冻,洗干净,煮熟的肉以后,得了李斯特菌引起的脑
图片尺寸1280x1280
李斯特菌:冰箱里的隐形"杀手"
图片尺寸2677x1506
李斯特菌的威力!冰箱常见的使用误区!下面3个冰箱使用的常见
图片尺寸1440x1920
冰箱李斯特菌判断与防范🦠
图片尺寸720x960
警惕冰箱里的健康隐患
图片尺寸1242x1660
冰箱里的"隐形杀手"李斯特菌,你知道吗?
图片尺寸810x1050
夏日谨防"冰箱杀手"李斯特菌# 夏日炎炎,很多人不管什么食物都往里
图片尺寸512x512
如何清洁冰箱并预防李斯特菌?
图片尺寸1364x1728
注意|小心冰箱变"病箱"!秋季警惕致命的李斯特菌!
图片尺寸3800x5700
夏天食物别放冰箱太久,小心李斯特菌
图片尺寸720x960
李斯特菌:冰箱中的隐患及孕妇的防护措施
图片尺寸1080x691
冰箱≠保险箱 致命李斯特菌就藏在你家冰箱里!
图片尺寸1280x720